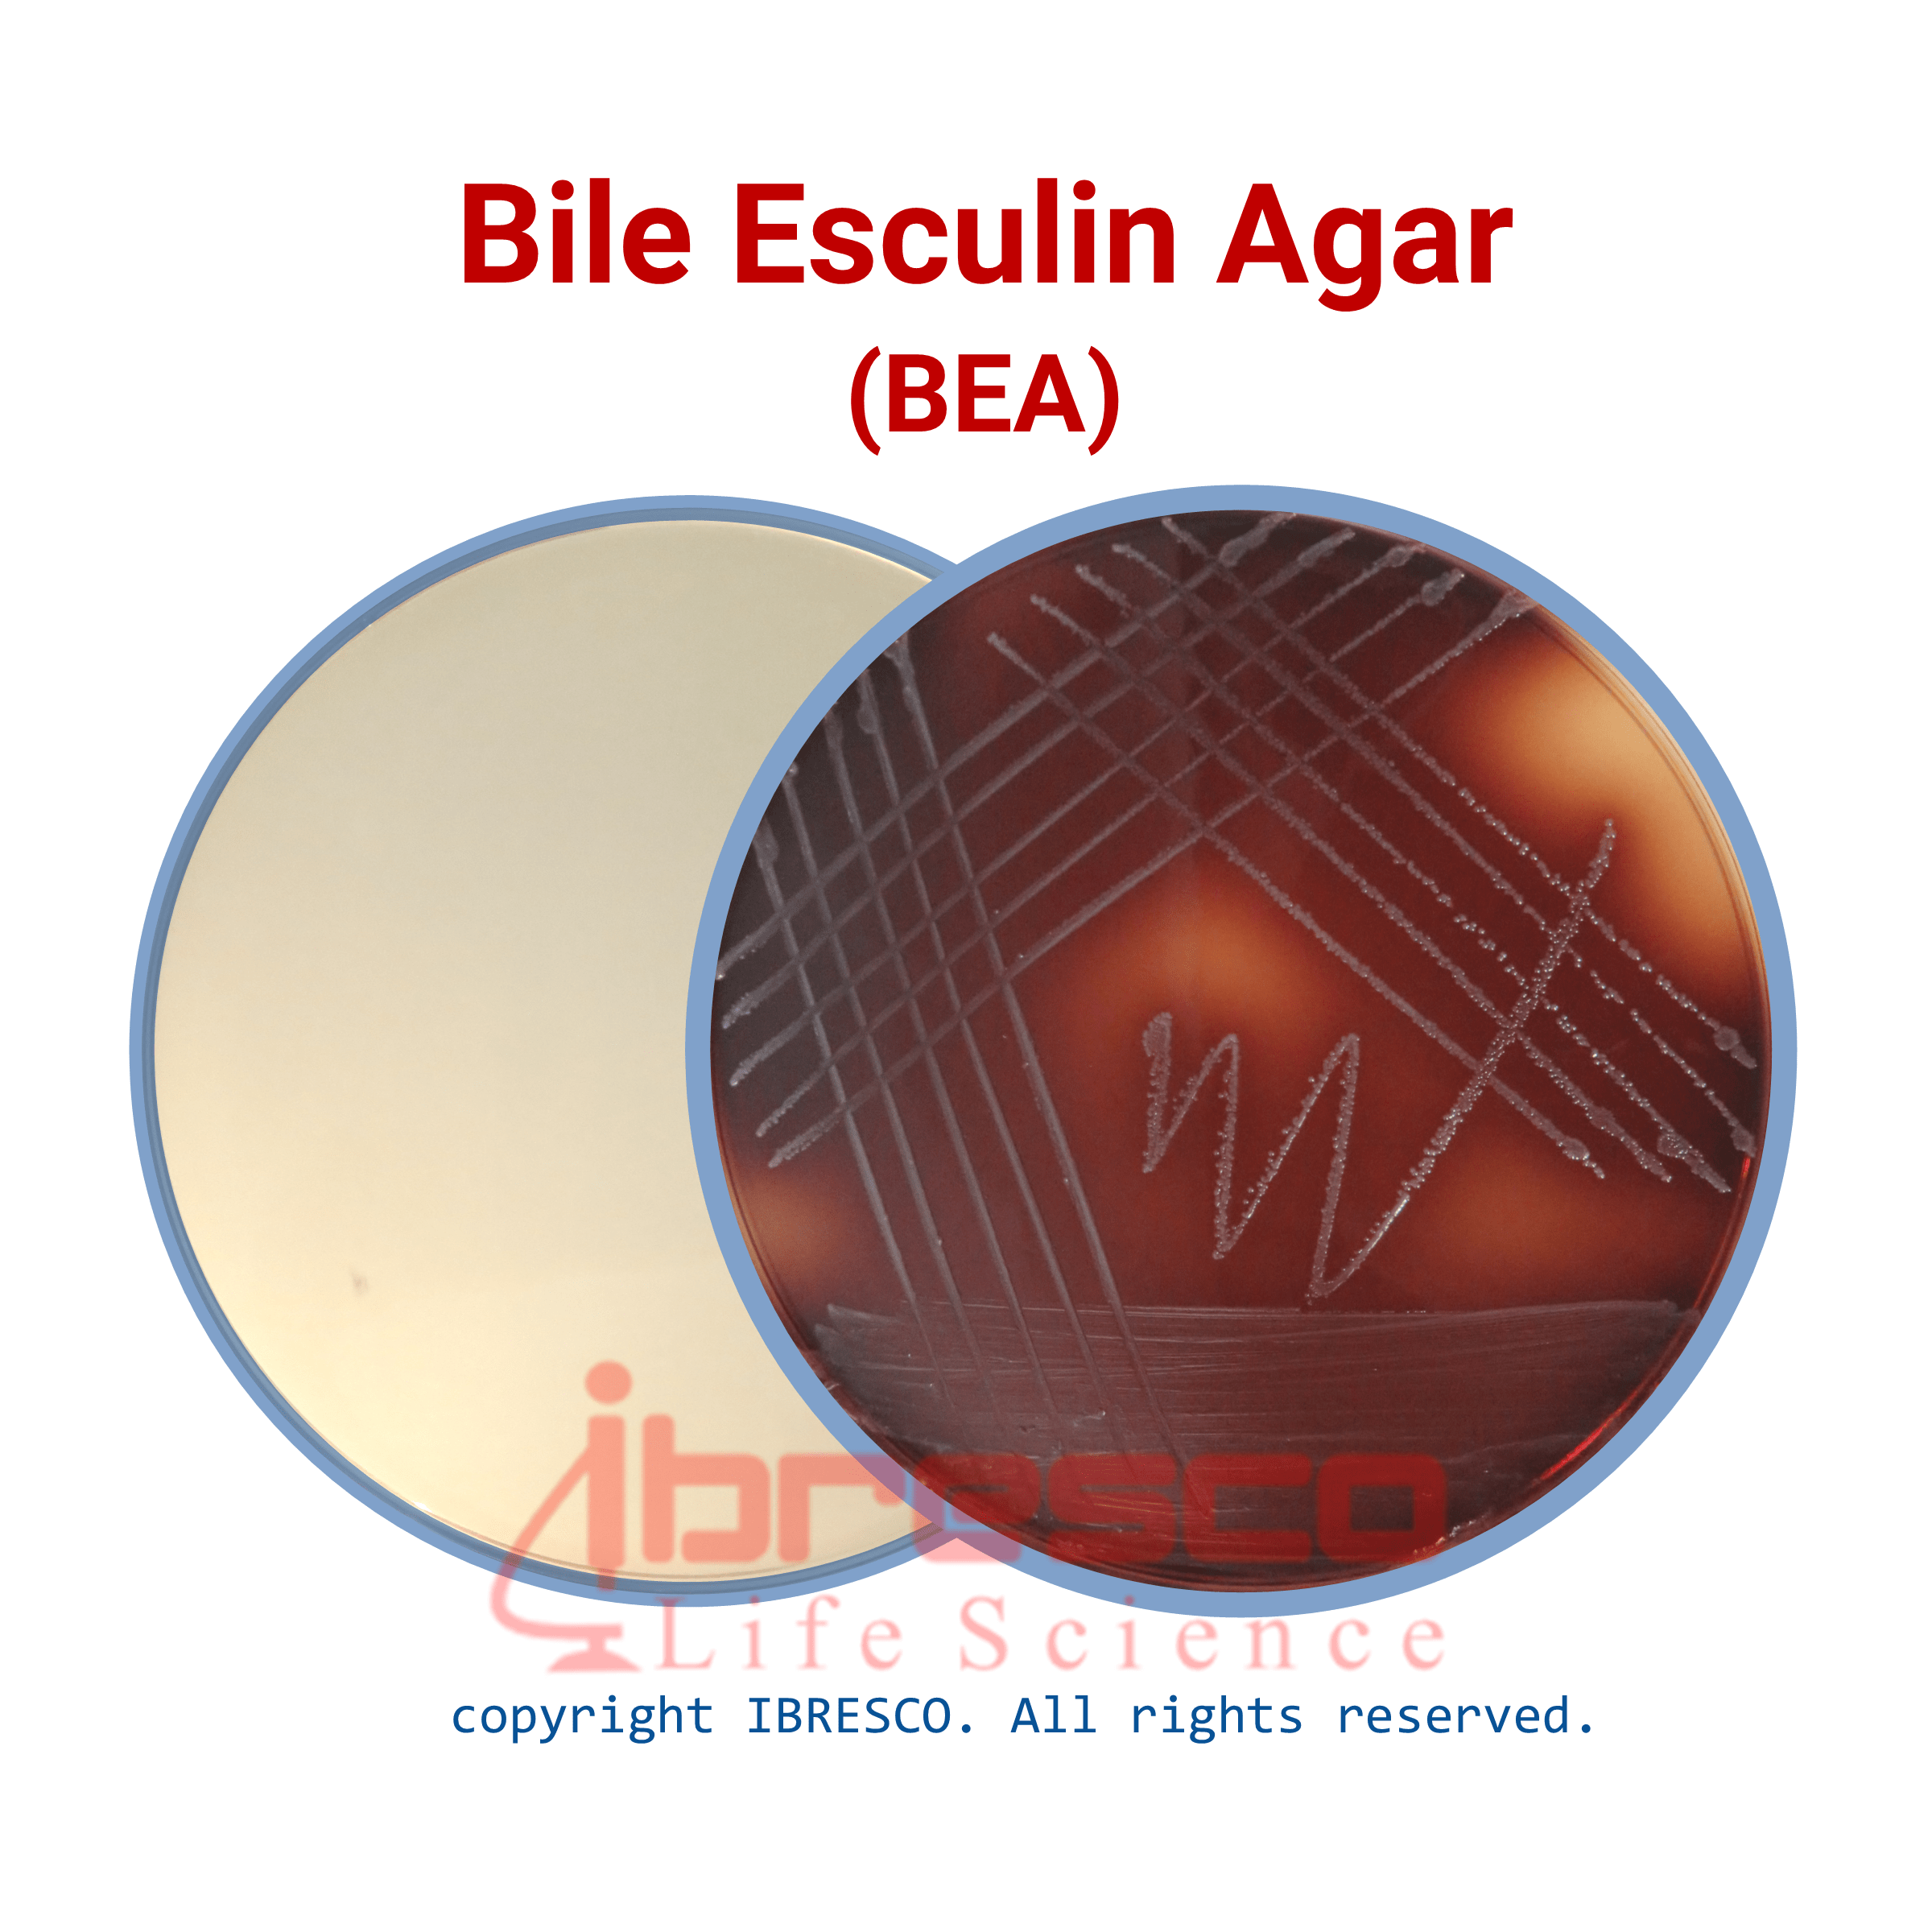
Bile Esculin Agar Ibresco Bile Esculin Agar Ibresco

If you are having a hard time accessing the Bile page, Our website will help you. Find the right page for you to go to Bile down below. Our website provides the right place for Bile.

https://forum.doctissimo.fr › sante › Digestion-brulures-estomac-RGO › reflux-…
Il y a toujours de la bile puisqu elle est s cr t e par le foie en permanancs donc il faut bien en faire quelque chose Lors de l op ration un raccordement est fait entre le foie et le bas de
https://forum.doctissimo.fr › sante › ventre-estomac-ulceres › irritable-biliaire-d…
En France ce m dicament porte galement le nom de Questran Par contre il n a pas l autorisation de prescription en dehors de 2 indications les hypercholest rol mies les

https://forum.doctissimo.fr › sante › ventre-estomac-ulceres › drain-vesicule-bi…
De plus j ai galement une b ance du cardia la jonction entre l estomac et l oesophage ne se faisant pas correctement la bile remonte par l galement je vais de surprises en surprises

https://forum.doctissimo.fr › sante › Digestion-brulures-estomac-RGO › reflux-…
Bonjour Pour ma part lors de la gastroscopie le chirurgien m a enlev entre 200 300 mg de bile de l estomac D o le diagnostic de reflux biliaire majeure Depuis il me change le

https://forum.doctissimo.fr › sante › medecines-douces › degorger-quelles-pla…
Bonjour Pour nettoyer le foie il faut faciliter l limination de la bile qui contient tous les m tabolites produits par le foie en utilisant des plantes chol r tiques facilitant la s cr tion de bile et

https://forum.doctissimo.fr › psychologie › insomnie-sommeil › reveil-sensatio…
Elle ne sait pas pourquoi elle s etouffe sa lui prend d un coup et elle ne veut pas aller chez le docteur donc j essaye de trouver des personnes ayant v cu la m me chose j essaye juste de
https://forum.doctissimo.fr › sante › cancers
Je n aurais jamais cru avoir envie ou pouvoir faire a C est aujourd hui que tout vient de s achever que je ressens l envie de le faire j ignore pourquoi Cette pouvantable maladie est un des
https://forum.doctissimo.fr › sante › Digestion-brulures-estomac-RGO › operati…
Je suis toujours emb t par ces mini reflux au go t amer toute la journ e j ai ce gout qui remontent quand m me il me semble je pense que c est de la bile Ca me me brule l oesophage au

https://forum.doctissimo.fr › sante › SEP
La bile fournit la principale voie d excr tion des m tabolites toxiques du cholest rol et des d chets lipidiques Elle est aussi n cessaire la digestion et l absorption efficaces des graisses
Thank you for visiting this page to find the login page of Bile here. Hope you find what you are looking for!